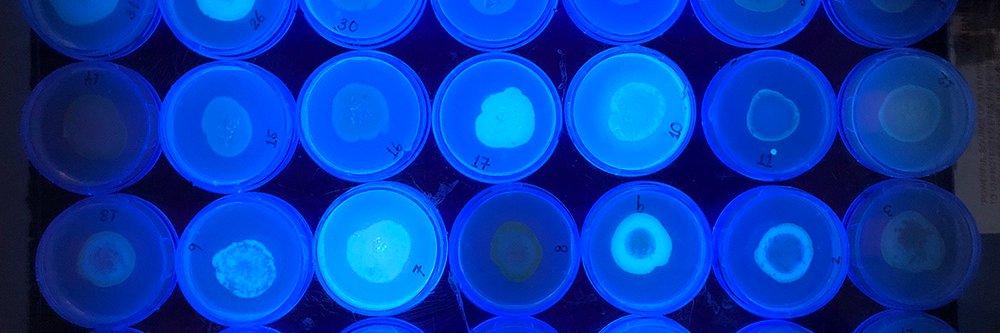
Pukkila-Worley Lab is also @rpwlab.bsky.social banner

Stoked to share our companion stories, now out in @ImmunityCP and @CellReports! We characterize an enzymatic TIR protein as an immune sensor in animals, showing that it is a guard protein in an effector-triggered immune response. cell.com/immunity/fullt… cell.com/cell-reports/f… 1/